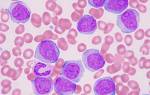

Анатомия области колена
Колено — часть нижней конечности между бедром и голенью. Верхняя граница коленной области находится на 4-6 см выше коленной чашечки, а нижняя — на уровне бугристости большеберцовой кости. Передняя и задняя части колена ограничены вертикальными линиями, проведенными через задние края мыщелков бедренной кости. Основу коленной области составляет коленный сустав.
Хруст и щелчки в колене — распространённая проблема, с которой сталкиваются многие люди. Врачи отмечают, что такие звуки могут возникать по различным причинам. Одной из наиболее частых является наличие газовых пузырьков в синовиальной жидкости, которые лопаются при движении. Однако, если хруст сопровождается болью или отёком, это может указывать на более серьёзные патологии, такие как остеоартрит, повреждение мениска или хондромаляция.
При ходьбе, сгибании и разгибании колена хруст может быть нормальным явлением, особенно у спортсменов. Тем не менее, если щелчки становятся постоянными и вызывают дискомфорт, важно обратиться к специалисту для диагностики. Врач может назначить рентген или МРТ для выявления возможных повреждений суставов. Важно не игнорировать такие симптомы, так как своевременное обращение к врачу может предотвратить развитие более серьёзных заболеваний.
https://youtube.com/watch?v=rMft_dcAVVI
Передняя область колена
Внешними ориентирами передней части колена служат надколенник, бугристость большеберцовой кости, надмыщелки и мыщелки бедренной кости, а также головка малоберцовой кости.
В передней части колена находятся:
- кожа и подкожно-жировая клетчатка;
- фасции;
- сухожилия мышц бедра;
- надколенник.
Кожа и подкожно-жировая клетчатка
Кожа на передней части колена плотная и подвижная, надколенник легко прощупывается. Область хорошо кровоснабжается. Жировая ткань развита слабо, в ней проходят поверхностные кровеносные и лимфатические сосуды, а также нервы. Медиальная часть колена иннервируется подкожным нервом, центральная — кожными ветвями бедренного нерва, латеральная — латеральным кожным нервом бедра.
Фасции
Фасция — это оболочка из соединительной ткани. Колено покрыто собственной и поверхностной фасциями. Собственная фасция — продолжение широкой фасции бедра. Под ней находится сосудистая сеть, обеспечивающая кровоснабжение передних отделов коленного сустава. Поверхностная фасция состоит из двух листков, между которыми расположены подкожные сумки, выстланные синовиальной оболочкой и заполненные синовиальной жидкостью.
Сухожилия мышц бедра
В области колена проходит сухожилие четырехглавой мышцы бедра, обвивающее надколенник и прикрепляющееся к большеберцовой кости, выполняя также функцию связки надколенника.
Надколенник
Надколенник — самая крупная сесамовидная кость в человеческом скелете, расположенная в сухожилии четырехглавой мышцы бедра. В его структуре выделяют верхушку и основание. Задняя поверхность надколенника соприкасается с надколенниковой поверхностью бедренной кости.
| Симптом | Возможные причины | Патологии, которые могут вызывать симптом |
|---|---|---|
| Хруст в колене при ходьбе | Остеоартрит, повреждение хряща, сухожильный тендинит, слабость мышц, избыточный вес | Остеоартрит, ревматоидный артрит, синовит, повреждение мениска, повреждение связок (например, передней крестообразной связки — ПКС) |
| Хруст в колене при сгибании и разгибании | Остеоартрит, повреждение хряща, ганглион, возрастные изменения, недостаток синовиальной жидкости | Остеоартрит, менископатия, тендинит, бурсит |
| Хруст в колене при приседании | Остеоартрит, повреждение хряща, слабость мышц, нестабильность коленного сустава | Остеоартрит, повреждение мениска, повреждение связок (ПКС, ЗКС), пателлофеморальный болевой синдром |
| Щелканье в колене | Повреждение мениска, сухожильный тендинит, подвывих надколенника, остеохондроз | Повреждение мениска, повреждение связок, пателлофеморальный болевой синдром, синовит |
| Хруст и щелканье одновременно | Комбинация вышеперечисленных причин | Остеоартрит с сопутствующим повреждением мениска или связок, ревматоидный артрит |
Задняя область колена
Внешними ориентирами задней части колена служат контуры полуперепончатой, полусухожильной и двуглавой мышц бедра. В центре этой области находится подколенная ямка.
В задней части колена находятся следующие структуры:
- кожа и подкожно-жировая клетчатка;
- фасции;
- сухожилия;
- подколенная ямка.
Кожа и подкожно-жировая клетчатка
Кожа в задней области колена тонкая и подвижная. Жировая ткань хорошо развита, в ней расположены поверхностные нервы и сосуды.
Фасции
Подколенная фасция — продолжение широкой фасции бедра. Она плотная и содержит отверстия для нервов и сосудов.
Сухожилия
Сухожилие двуглавой мышцы бедра прикрепляется к головке малоберцовой кости, а сухожилие полусухожильной мышцы — к большеберцовой кости. Сухожилие полуперепончатой мышцы прикрепляется частично к медиальному мыщелку большеберцовой кости и частично к капсуле коленного сустава.
Подколенная ямка
Подколенная ямка ромбовидной формы ограничена сухожилиями. Дно образует капсула коленного сустава.
Подколенная ямка ограничена сухожилиями следующих мышц:
- полуперепончатая и полусухожильная мышцы;
- двуглавая мышца бедра;
- латеральная и медиальная головки икроножной мышцы.
В подколенной ямке располагается сосудисто-нервный пучок, общий малоберцовый нерв, глубокие лимфатические узлы и синовиальные сумки. Сосудисто-нервный пучок состоит из подколенной артерии, подколенной вены и большеберцового нерва. Наиболее поверхностно расположен нерв, чуть глубже — вена, а наиболее глубоко — артерия.
Хруст и щелчки в колене — распространённое явление, о котором часто говорят люди. Многие замечают, что их колени издают характерные звуки при ходьбе, сгибании или разгибании, а также во время приседаний. Причины такого хруста могут быть разнообразными. Одной из наиболее распространённых является трение суставных поверхностей, когда хрящи изнашиваются или повреждаются. Это может происходить из-за возрастных изменений, травм или чрезмерных нагрузок на сустав.
Кроме того, хруст может быть связан с наличием газовых пузырьков в синовиальной жидкости, которые при движении лопаются, создавая характерный звук. Однако иногда хруст и щелчки могут указывать на более серьёзные патологии, такие как остеоартрит, менископатия или воспалительные процессы в суставе. Если хруст сопровождается болью или ограничением движений, важно обратиться к врачу для диагностики и назначения адекватного лечения.

Коленный сустав
Коленный сустав — самый крупный и сложный сустав в теле. Он образован бедренной костью, надколенником и большеберцовой костью. Малоберцовая кость, хотя и имеет головку в области колена, не участвует в формировании сустава. Суставные поверхности мыщелков бедренной кости соединяются с суставными площадками большеберцовой кости, покрытыми хрящом, что обеспечивает плавное скольжение. Между суставными поверхностями находятся мениски, которые улучшают конгруэнтность сустава и выполняют амортизирующую функцию. Внешние края менисков утолщены и к ним прикрепляется суставная капсула. В менисках выделяют три зоны в зависимости от кровоснабжения: красную, красно-белую и белую.
Связки, укрепляющие коленный сустав:
- связка надколенника;
- малоберцовая коллатеральная связка;
- большеберцовая коллатеральная связка;
- косая подколенная связка;
- дугообразная подколенная связка;
- поперечная связка колена;
- передняя и задняя крестообразные связки;
- задняя мениско-бедренная связка.
Основная задача связок — поддержание стабильности и содействие движениям.
В коленном суставе возможны следующие движения:
- сгибание;
- разгибание;
- наружная и внутренняя ротация.
Суставная полость покрыта синовиальной оболочкой, образующей завороты, которые увеличивают полость сустава. При воспалениях в этих заворотах может скапливаться жидкость. Верхние и передние завороты удобны для пункции. Синовиальная оболочка также формирует полости с синовиальной жидкостью — синовиальные сумки, которые служат дополнительными амортизаторами. Воспаление в синовиальных сумках (бурсит) может негативно сказаться на состоянии сустава.
Какие структуры могут хрустеть в колене?
Как правило, хруст и щелчки в колене возникают при повреждении твердых структур. При поражении мягких тканей хруст может быть вызван нарушением конгруэнтности суставных поверхностей.
Структуры, повреждение которых может привести к хрусту в колене:
- дистальный отдел бедренной кости;
- проксимальный отдел большеберцовой кости;
- надколенник;
- мениски;
- суставной хрящ;
- суставная капсула.
Хруст может возникнуть как при повреждении одной из перечисленных структур, так и при одновременном поражении нескольких из них.
Чаще всего хруст в колене связан с повреждением структур в области колена. Однако иногда этот симптом может быть вызван заболеваниями, затрагивающими весь организм, например, при ожирении.
Основные причины хруста в колене:
- гонартроз;
- повреждение менисков;
- ревматоидный артрит;
- подагрический артрит;
- гипермобильность коленного сустава;
- нарушение фосфорно-кальциевого обмена;
- ожирение;
- хондроматоз;
- бурсит;
- рассекающий остеохондрит;
- остеофиты;
- вывих;
- перелом костей коленного сустава;
- повреждение связок;
- повреждение сухожилий;
- хондромаляция надколенника.
Гонартроз характеризуется дистрофическими изменениями и изнашиванием суставного хряща, что может привести к инвалидности. Заболевание чаще встречается у женщин и с возрастом риск его развития возрастает.
Основная причина гонартроза — дисбаланс между механическим давлением на сустав и восстановительными способностями тканей.
Виды гонартроза:
- Первичный гонартроз — может возникнуть из-за гормонального дисбаланса, генетических и метаболических нарушений.
- Вторичный гонартроз — развивается под воздействием травм, повреждений менисков и других факторов.
С прогрессированием заболевания повреждение суставных структур становится более выраженным.
Стадии гонартроза:
- 1 стадия. Первичное поражение гиалинового хряща, клетки теряют функции.
- 2 стадия. Появляются трещины в хряще, раздражающие синовиальную оболочку.
- 3 стадия. Гиперплазия синовиальной оболочки, появляются остеофиты.
- 4 стадия. Разрушение субхондральной хрящевой пластинки, возможны кисты.
- 5 стадия. Образование грануляционной ткани, значительная деформация суставных поверхностей.
Первым симптомом гонартроза является боль в колене, усиливающаяся при нагрузках. В начальных стадиях боли чаще беспокоят утром, а в течение дня проходят. Хруст при движении связан с трением пораженных суставных поверхностей и может сопровождаться ограничением движений.
Повреждение менисков — распространенная травма коленного сустава, чаще всего затрагивающая внутренний мениск. Повреждения могут возникать как при прямом, так и непрямом воздействии.
Клинические проявления повреждения менисков:
- Блокада сустава — временное сопротивление при разгибании.
- Боли в колене — особенно при нагрузке.
- Симптом «щелчка» — возникает при ходьбе.
- Выпот в полости сустава — из-за воспаления.
- Гемартроз — скопление крови в суставе.
Заживление после повреждения мениска возможно только в паракапсулярной зоне. В аваскулярной зоне требуется хирургическое вмешательство.
Ревматоидный артрит — аутоиммунное заболевание, характеризующееся хроническим воспалением синовиальной оболочки. Чаще встречается у женщин и может проявляться как моноартрит или полиартрит.
Причины ревматоидного артрита неясны, но предполагаются травмы и переохлаждение.
Основные симптомы ревматоидного артрита:
- Боль при движении и пальпации.
- Припухлость колена из-за накопления жидкости.
- Утренняя скованность в суставах.
- Деформация коленных суставов.
- Контрактура — ограничение движений.
- Атрофия четырехглавой мышцы бедра.
Подагрический артрит возникает из-за нарушения обмена мочевой кислоты, что приводит к накоплению солей. Чаще поражает мужчин старше 40-50 лет.
Подагрический артрит проявляется приступами, сопровождающимися интенсивной болью в суставе. В межприступный период симптомы уменьшаются, но хруст и ограничение движений сохраняются.
Синдром гипермобильности коленных суставов характеризуется повышенной гибкостью и подвижностью, часто из-за генетических нарушений. Это состояние связано с нарушением синтеза коллагена, что приводит к растяжению связок и быстрому изнашиванию хряща.
Хруст в колене — основной симптом, часто сопровождающийся болью при нагрузках. В области коленного сустава может наблюдаться припухлость.
Нарушение фосфорно-кальциевого обмена негативно сказывается на состоянии костной ткани.
Симптомы нарушения фосфорно-кальциевого обмена:
- хруст и щелчки в колене;
- ограничение подвижности;
- боль при движениях и в покое;
- деформация сустава.
Ожирение — избыточная масса тела, часто сопровождающаяся проблемами с коленями. При увеличении веса на сустав оказывается большая нагрузка, что способствует его разрушению.
Степени ожирения:
- 1 степень. Нормальная масса тела превышена на 20-30%.
- 2 степень. Избыточная масса составляет 30-40%.
- 3 степень. Масса тела превышает норму на 50-99%.
- 4 степень. Превышение идеальной массы тела на 100% и более.
Чем выше степень ожирения, тем выше риск поражения суставных структур.
Хондроматоз коленного сустава — заболевание, при котором происходит метаплазия хрящевой ткани с образованием хрящевых тел, которые могут блокировать сустав. Хондроматоз может быть врожденным или приобретенным.
Симптомы хондроматоза:
- боль в коленном суставе;
- хруст при движении;
- ограниченность движений;
- частые блокады;
- припухлость.
Бурсит — воспаление синовиальных сумок, чаще всего препателлярной. Пусковым фактором являются травмы или чрезмерные нагрузки.
Клинические проявления бурсита:
- боль в области колена;
- припухлость;
- ограниченность движений;
- хруст при движении.
Рассекающий остеохондрит — отслаивание хрящевой пластинки, чаще всего локализуется в коленном суставе. Причины неясны, но предполагаются травмы и нарушения кровоснабжения.
Стадии рассекающего остеохондрита:
- 1 стадия. Воспаление синовиальной оболочки, боль и припухлость после нагрузки.
- 2 стадия. Боль становится более выраженной.
- 3 стадия. Постоянная боль, возможна блокада сустава.
Остеофиты — разрастания костной ткани, возникающие при длительных нагрузках и остеоартрозе. Образование остеофитов может быть бессимптомным, но при увеличении размеров возможно травмирование сустава.
Вывихи колена встречаются реже, чем вывихи других суставов. При вывихе слышен щелчок из-за смещения суставных поверхностей.
Виды вывихов коленного сустава:
- Вывих голени. Редкое заболевание с тяжелым течением.
- Вывих головки малоберцовой кости. Может осложниться повреждением нерва.
- Вывих надколенника. Чаще всего вызван травмами.
Переломы, сопровождающиеся хрустом, включают переломы дистального отдела бедренной кости, проксимального отдела голени и надколенника. Хруст слышен как в момент перелома, так и при движении.
Поражение связок коленного сустава может быть тяжелым, приводя к нестабильности и хрусту.
Поражение сухожилий также может быть причиной хруста, особенно при повреждении сухожилия четырехглавой мышцы.
Хондромаляция надколенника — разрушение хряща на задней поверхности надколенника, часто встречается у спортсменов.
Основные специалисты, занимающиеся диагностикой хруста в колене, — травматолог, ортопед и ревматолог. Они проводят осмотр, учитывают жалобы и симптомы, что помогает установить диагноз. Для подтверждения назначаются лабораторные и инструментальные исследования.
Другие специалисты:
- семейный врач;
- терапевт;
- диетолог.
Диагностика включает множество методов исследования.
Методы диагностики:
- клиническое обследование;
- общий анализ крови;
- биохимический анализ крови;
- общий анализ мочи;
- УЗИ коленного сустава;
- рентген;
- исследование синовиальной жидкости;
- артроскопия;
- КТ;
- МРТ;
- сцинтиграфия.
Обследование начинается с анализа жалоб. Хруст в колене чаще беспокоит пациентов старше 40 лет. Важно учитывать наличие травм и заболеваний опорно-двигательного аппарата.
При осмотре могут быть выявлены:
- припухлость;
- гематома;
- деформация колена;
- симметричность изменений.
Крепитация может быть ощутима при пальпации. Аускультация проводится во время активных или пассивных движений.
Общий анализ крови показывает изменения, характерные для воспалительных процессов. Биохимический анализ исследует показатели состояния органов и тканей.
УЗИ — высокоинформативный метод, особенно для мягких тканей. Признаки патологии, которые можно обнаружить при УЗИ:
- наличие выпота;
- воспаление синовиальной оболочки;
- разрывы сухожилий и связок;
- поражение менисков.
Рентгенологическое исследование часто назначается для диагностики, но не отображает поражение мягких тканей.
Рентгенологические признаки:
- изменение положения костей;
- сужение суставной щели;
- очаги деструкции.
Исследование синовиальной жидкости проводится в лаборатории. Изменения могут включать цвет, прозрачность и клеточный состав.
Артроскопия — хирургическое вмешательство для диагностики и лечения повреждений.
Компьютерная томография позволяет выявить переломы и воспаление синовиальной оболочки.
МРТ позволяет диагностировать:
- отек околосуставных тканей;
- наличие выпота;
- повреждения связок.
Сцинтиграфия основана на введении радиофармацевтических препаратов, но точный диагноз установить невозможно.
Для устранения хруста необходимо лечить патологии, вызывающие этот симптом. Терапия должна быть комплексной.
Лечение должно включать:
- соблюдение диеты;
- медикаментозное лечение;
- хирургическое лечение;
- восстановительное лечение.
Диета важна при ожирении и подагре. Для нормализации фосфорно-кальциевого обмена следует увеличить потребление продуктов, богатых кальцием и фосфором.
Медикаментозное лечение:
| Группа препаратов | Представители | Механизм действия | Способ применения |
| НПВС | ибупрофен, диклофенак | Обезболивание, снятие отека | местно, перорально |
| Кортикостероиды | преднизолон, гидрокортизон | Противовоспалительный эффект | внутрисуставные инъекции |
| Противоподагрические | аллопуринол, колхицин | Угнетение образования мочевой кислоты | перорально |
| БПВП | метотрексат, циклоспорин | Замедление разрушительных процессов | внутримышечные инъекции |
| Витаминно-минеральные комплексы | различные комплексы | Восстановление структуры тканей | перорально |
| Хондропротекторы | хондроитин, глюкозамин | Питание хрящевой ткани | перорально, инъекции |
Хирургическое лечение назначается при неэффективности консервативных методов.
Виды хирургических вмешательств:
- артротомия;
- тенорафия;
- артропластика;
- лечебная пункция;
- синовэктомия;
- артроскопия;
- остеосинтез;
- менискэктомия.
Восстановительный этап включает методы для восстановления функций сустава.
Методы восстановления:
- ЛФК — важный этап лечения.
- Физиотерапия — использование физических факторов.
- Плавание — положительно влияет на обменные процессы.
Хруст в колене чаще всего возникает при сгибании и разгибании, а также при приседании. Он может быть физиологическим или патологическим, связанный с трением пораженных суставных поверхностей.
Хруст в коленях у ребенка может возникнуть из-за травм или патологий.
Причины хруста в колене у ребенка:
- Врожденные патологии — нарушения развития.
- Травмы — могут привести к серьезным повреждениям.
- Недостаток элементов в питании — может привести к рахиту.
- Ювенильный ревматоидный артрит — воспалительное заболевание.
- Остеопороз — снижение плотности костной ткани.
Хруст в коленях при подъеме по лестнице возникает из-за нагрузки на сустав.
Патологии, вызывающие хруст при подъеме по лестнице:
- Гонартроз — разрушение хряща.
- Повреждение менисков — разрыв может вызвать хруст.
- Ревматоидный артрит — воспаление синовиальной оболочки.
- Поражение связок — нестабильность может вызывать хруст.
При появлении хруста и щелчков при подъеме по лестнице необходимо обратиться к врачу.
Припухлость и хруст в колене указывают на воспалительный процесс.
Причины опухания и хруста:
- Артрит — воспалительное заболевание.
- Повреждение менисков — разрывы могут привести к хрусту.
- Бурсит — воспаление синовиальных сумок.
- Гонартроз — возрастные изменения.
При появлении этих симптомов следует провести обследование.
Хруст в коленях после бега может быть вызван неправильной техникой или неподходящей обувью.
Патологии, вызывающие хруст после бега:
- Остеоартроз — разрушение хряща.
- Растяжение связок — может произойти без разминки.
- Повреждение менисков — распространенная травма.
- Бурсит — воспаление из-за нагрузки.
- Внутрисуставные свободные тела — фрагменты хряща.
Если хруст возникает регулярно и сопровождается болью, необходимо обратиться к врачу. Рекомендуется заменить бег на менее нагружающие виды спорта, такие как плавание.

Основные причины хруста в колене
Хруст в колене чаще всего возникает из-за повреждения структур коленного сустава. В некоторых случаях он может быть связан с заболеваниями, влияющими на весь организм, например, ожирением.
Основные причины хруста в колене:
- гонартроз;
- травмы менисков;
- ревматоидный артрит;
- подагрический артрит;
- гипермобильность сустава;
- нарушения обмена фосфора и кальция;
- избыточный вес;
- хондроматоз;
- бурсит;
- рассекающий остеохондрит;
- остеофиты;
- вывих сустава;
- переломы костей сустава;
- повреждения связок;
- травмы сухожилий;
- хондромаляция надколенника.
Гонартроз как причина хруста в колене
Гонартроз — заболевание коленного сустава, характеризующееся дистрофическими изменениями, нарушением питания суставных тканей, износом хряща и деформацией сустава. Оно может привести к инвалидности и потере трудоспособности. Гонартроз чаще встречается у женщин и возрастает с годами.
Основная причина гонартроза — несоответствие между механическим давлением на сустав и восстановительными способностями тканей.
Типы гонартроза:
- Первичный гонартроз развивается из-за гормонального дисбаланса, генетических и метаболических нарушений, а также проблем с кровообращением.
- Вторичный гонартроз возникает под воздействием внутрисуставных (травмы, переломы, повреждения менисков) и внесуставных факторов (патологии тазобедренного сустава, вывихи, неправильно выполненные артродезы).
С прогрессированием заболевания повреждения суставных структур становятся более выраженными.
Стадии гонартроза:
- 1 стадия. Первичное поражение гиалинового хряща, клетки начинают дегенерировать и теряют способность к восстановлению.
- 2 стадия. В хряще появляются трещины, достигающие субхондральной хрящевой пластинки, образуются фрагменты хряща, вызывающие воспаление синовиальной оболочки.
- 3 стадия. Увеличение синовиальной оболочки и появление краевых остеофитов.
- 4 стадия. Разрушение субхондральной хрящевой пластинки, образование кист и утолщение суставной капсулы.
- 5 стадия. Формирование грануляционной ткани в области поражения кости, значительная деформация суставных поверхностей.
Первый признак гонартроза — боль в коленном суставе, усиливающаяся при подъеме по лестнице, ходьбе, приседаниях и переохлаждении. Боль может усиливаться в сырую и холодную погоду. На ранних стадиях боли чаще беспокоят утром, а в течение дня утихают. При движении можно услышать хруст из-за трения поврежденных суставных поверхностей, что ограничивает движения из-за ущемления гипертрофированных ворсинок синовиальной оболочки. Также развиваются контрактуры, затрудняющие сгибание и разгибание ноги, может наблюдаться припухлость сустава. На последних стадиях пациенты испытывают значительные трудности при ходьбе.
Повреждение менисков как причина хруста в колене
Повреждение менисков – распространенная травма коленного сустава. Внутренний мениск страдает чаще (80-90% случаев) из-за своей анатомической структуры, которая ограничивает его подвижность. Наружный мениск повреждается реже, но его травмы вызывают более серьезные проблемы, влияя на стабильность сустава.
Мениски могут пострадать от прямых и непрямых травмирующих факторов. Основные причины включают резкое разгибание колена, прыжки и резкие повороты голени.
Клинические проявления повреждения менисков:
- Блокада сустава – ощущение сопротивления при разгибании, часто временная, возникает при приседаниях или ходьбе.
- Боль в колене, усиливающаяся при ходьбе или нагрузке, особенно при подъеме и спуске по лестнице.
- Симптом «щелчка» – возникает при ходьбе, связан с «перекатыванием» голени через поврежденный мениск.
- Выпот (скопление синовиальной жидкости) в полости коленного сустава, связанный с воспалением синовиальной оболочки.
- Гемартроз – скопление крови в полости коленного сустава.
Восстановление возможно, если травма произошла в паракапсулярной (красной) зоне, хорошо кровоснабжаемой. Если повреждена аваскулярная (белая) зона мениска, заживление не произойдет, и потребуется хирургическое вмешательство.
Ревматоидный артрит коленного сустава
Ревматоидный артрит — аутоиммунное заболевание, при котором иммунная система вырабатывает антитела, разрушающие собственные ткани. Оно сопровождается хроническим воспалением суставов, особенно синовиальной оболочки. Заболевание чаще встречается у женщин и может затрагивать людей всех возрастов. Ревматоидный артрит проявляется как моноартрит (поражение одного сустава) или полиартрит (несколько суставов).
Причины ревматоидного артрита остаются неясными, но предполагается, что его могут спровоцировать травмы, переохлаждение и физическое перенапряжение.
На ранних стадиях пациенты могут выполнять повседневные нагрузки, тогда как на поздних движений становится меньше или они становятся невозможными.
Основные симптомы ревматоидного артрита коленного сустава:
- Боль при движении и ощупывании.
- Припухлость колена из-за накопления жидкости и отечности тканей.
- Утренняя скованность в суставах, зависящая от тяжести заболевания.
- Деформация коленных суставов.
- Контрактура коленного сустава — ограничение движений из-за воспалительного процесса.
- Атрофия четырехглавой мышцы бедра — нарушение питания и функций мышечных клеток.
Подагрический артрит коленного сустава
Подагрический артрит коленного сустава возникает из-за нарушения обмена мочевой кислоты, что приводит к накоплению её солей в тканях и характерным клиническим проявлениям. Ураты могут накапливаться из-за их избыточного образования или проблем с выведением. Чаще всего заболевание затрагивает мужчин старше 40-50 лет, а локализация в колене встречается редко.
Среди клинических форм подагрического артрита выделяют острый и хронический. Заболевание проявляется приступами, которые обычно возникают ночью и сопровождаются сильной болью в суставе, трудно поддающейся обезболиванию. Между приступами симптомы ослабевают. При движении в коленном суставе слышен хруст, движения ограничены. В области пораженного сустава наблюдаются припухлость, покраснение и местное повышение температуры.
Синдром гипермобильности коленных суставов
Синдром гипермобильности коленных суставов, или гипермобильный синдром, характеризуется повышенной гибкостью и подвижностью коленного сустава. Чаще всего он обусловлен генетическими факторами (первичный гипермобильный синдром). В некоторых случаях повышенная подвижность может быть вторичной, возникая из-за воспалительных процессов, неврологических или гормональных нарушений. Заболевание связано с нарушениями синтеза коллагена, что приводит к частым растяжениям связок, вывихам и быстрому износу суставного хряща.
Основной признак состояния — хруст в колене, часто сопровождающийся болями во время физической активности. В области коленного сустава может наблюдаться отечность из-за воспаления синовиальной оболочки. При клиническом обследовании выявляется избыточная подвижность сустава.
Нарушение фосфорно-кальциевого обмена как причина хруста в колене
Кальций и фосфор важны для организма, так как костная ткань является их основным хранилищем. Недостаток этих минералов или неправильное соотношение негативно сказывается на здоровье скелета.
Основные признаки нарушений обмена фосфора и кальция:
- хруст и щелчки в коленях при движении;
- ограниченная подвижность;
- болезненные ощущения при движениях, а в серьезных случаях — даже в покое;
- деформация суставов.
Проблемы с обменом фосфора и кальция могут возникать из-за врожденных аномалий или неправильного питания (недостаток кальция и фосфора в рационе).
Ожирение
Ожирение — это увеличение массы тела из-за избыточного накопления жировой ткани. Оно часто приводит к проблемам с коленными суставами, включая хруст при движении. Хруст возникает из-за повышенной нагрузки на сустав, что приводит к его износу. Своевременная борьба с лишним весом может предотвратить суставные заболевания.
Причины ожирения включают малоподвижный образ жизни, переедание, генетическую предрасположенность и гормональные нарушения.
Существует 4 степени ожирения:
- 1 степень. Масса тела превышает норму на 20–30%.
- 2 степень. Избыточный вес составляет 30–40%.
- 3 степень. Масса тела превышает норму на 50–99%.
- 4 степень. Превышение идеальной массы тела на 100% и более.
С увеличением степени ожирения возрастает риск повреждения суставов и хруста в коленях при движении.
Хондроматоз коленного сустава
Хондроматоз коленного сустава — это патологическое состояние, при котором хрящевая ткань метаплазируется, заменяя одни клетки другими и образуя хрящевые тела. Эти образования располагаются внутри сустава и могут вызывать его блокаду. Хондроматоз бывает врожденным, связанным с нарушениями эмбрионального развития, и приобретенным, возникающим под воздействием внешних факторов. Врожденная форма встречается редко, а в некоторых случаях может озлокачествляться, проявляясь как опухоль.
Существует две формы хондроматоза: стабильная и прогрессирующая. При стабильной форме образуется от 10 до 25 хрящевых тел, после чего процесс останавливается. Прогрессирующая форма характеризуется постоянным образованием новых хрящевых тел, которые накапливаются в суставе и могут полностью покрыть синовиальную мембрану.
Хондроматоз коленного сустава обычно проявляется односторонним поражением, а одновременное поражение обоих суставов наблюдается редко.
Основные симптомы хондроматоза коленного сустава:
- болевые ощущения в колене;
- хруст при движении;
- ограничение подвижности;
- частые блокировки сустава;
- отечность в области колена.
Первым признаком заболевания является боль, затем появляется хруст в колене при движении. С увеличением размеров хондромных тел хруст и боль усиливаются, также наблюдается визуальная деформация коленного сустава.
Бурсит коленного сустава
Бурсит — воспаление синовиальных сумок. Существует несколько видов бурсита коленного сустава, различающихся по месту воспаления. Бурситы могут быть поверхностными и глубокими. Чаще всего воспаляется препателлярная сумка над надколенником. Основные факторы развития бурсита — травмы колена и чрезмерные физические нагрузки. В некоторых случаях бурсит может быть инфекционным (септическим), когда патогенные микроорганизмы попадают в синовиальную сумку через кровь или при открытых травмах.
Клинические проявления бурсита коленного сустава:
- болевые ощущения в области колена;
- отечность;
- ограничение подвижности;
- хруст при движении.
Хруст при бурсите связан с воспалением синовиальных сумок. Точный диагноз часто устанавливается во время клинического осмотра. Одной из форм бурсита является киста Бейкера, или бурсит подколенной ямки. Это заболевание проявляется отечностью в задней части колена, ограничением движений и болевыми ощущениями при движении.
Рассекающий остеохондрит как причина хруста в колене
Рассекающий остеохондрит, или болезнь Кенига, — это состояние, при котором хрящевая ткань отделяется от кости, иногда полностью. В 95% случаев заболевание затрагивает коленный сустав.
Чаще всего рассекающий остеохондрит встречается у мужчин в возрасте 20–40 лет. Причины его возникновения не установлены, но основными факторами считаются травмы, нарушения кровообращения в колене и чрезмерные физические нагрузки.
Различают три стадии развития рассекающего остеохондрита коленного сустава:
- 1 стадия. Воспаление синовиальной оболочки, сопровождающееся болью и отечностью, обычно после физической нагрузки, исчезает в покое.
- 2 стадия. Боль усиливается и сохраняется длительное время.
- 3 стадия. Боль становится постоянной. При полном отделении хрящевого фрагмента он может стать свободным телом, что приводит к блокировке сустава и хрусту при движении.
После лечения симптомы, как правило, исчезают.
Остеофиты коленного сустава
Остеофит — это аномальное разрастание костной ткани, представляющее собой наросты на поверхности кости. Они чаще всего возникают из-за длительных нагрузок на коленный сустав, нарушений обмена веществ, особенно фосфорно-кальциевого, и остеоартроза. Также возможна наследственная предрасположенность к образованию остеофитов. Эти факторы ухудшают питание суставного хряща. Воспалительные процессы или травмы могут привести к его истончению. В ответ на это в областях с патологическими изменениями начинается разрастание хрящевой ткани, которая со временем превращается в костную. Обычно остеофиты формируются без явных симптомов, но с увеличением их размера может происходить травмирование сустава. Клинические проявления включают хруст в колене при движении, болевые ощущения и ограничение подвижности.
Вывихи коленного сустава
Вывихи коленного сустава встречаются реже, чем вывихи других суставов из-за прочной фиксации связками. Они могут быть полными или неполными (подвывих), в обоих случаях нарушается функциональность колена. При вывихе слышен характерный щелчок, возникающий из-за смещения суставных поверхностей.
Виды вывихов коленного сустава:
-
Вывих голени. Это редкое состояние характеризуется смещением костей голени относительно бедренной кости. Травма приводит к разрыву суставной капсулы, повреждению связок, суставных поверхностей, менисков, а также нервов и сосудов. Направление смещения может быть передним, задним, боковым (латеральным и медиальным) или смешанным, при этом чаще всего наблюдается передненаружное смещение. После травмы возникает резкая боль, сустав деформируется, активные движения невозможны, а пассивные могут быть опасны из-за риска повреждения сосудов или нервов. При полном вывихе нога остается в выпрямленном положении и выглядит укороченной, при подвывихе сохраняется сгибание и укорочения нет.
-
Вывих головки малоберцовой кости встречается крайне редко и обычно связан с разрывом межберцового синдесмоза. Чаще всего причиной является падение на согнутую ногу. Этот вывих может повредить малоберцовый нерв.
-
Вывих надколенника. Обычно возникает из-за травм или дисплазии надколенника, что может привести к латеропозиции. Выделяют травматический и привычный вывих надколенника. Травматический вывих может быть боковым, ротационным или вертикальным. Привычный вывих возникает повторно и может быть вызван незначительной травмой. Вывих надколенника сопровождается сильной болью, а положение конечности зависит от направления смещения: при боковом вывихе нога согнута, при ротационном — выпрямлена. Движения в коленном суставе ограничены.
Переломы костей, формирующих коленный сустав
К переломам с хрустом в коленном суставе относятся переломы дистального отдела бедренной кости, проксимального отдела большеберцовой кости и надколенника. Хруст слышен как в момент травмы, так и при движении в колене.
Перелом проксимального отдела большеберцовой кости встречается в пять раз чаще, чем переломы других костей коленного сустава. Обычно такие переломы сопровождаются повреждением мягких тканей и суставной капсулы. Смещение костных фрагментов может травмировать большеберцовый нерв или сосудисто-нервный пучок в области колена.
Перелом дистального отдела бедренной кости включает перелом мыщелков. Основные причины таких травм — падения с высоты, дорожно-транспортные происшествия и остеопороз, приводящий к снижению плотности костной ткани. Перелом мыщелков может быть внутрисуставным или внесуставным в зависимости от линии перелома.
Наиболее частая причина перелома надколенника — падение на согнутое колено или удар по передней части колена. Чаще встречается горизонтальный перелом, так как сухожилие четырехглавой мышцы бедра прикрепляется к верхней части надколенника и при травме тянет его вверх. Обычно наблюдается смещение отломков. Вертикальные и многооскольчатые переломы надколенника встречаются реже.
Поражение связок коленного сустава
Наиболее серьезным является повреждение коллатеральных и крестообразных связок коленного сустава, проявляющееся растяжением или полным разрывом. Такие травмы возникают при значительных нагрузках или резких движениях.
Повреждение связок приводит к нестабильности сустава, которая может быть передней, задней, медиальной или латеральной, в зависимости от места повреждения. В некоторых случаях возникает ротационная нестабильность, чаще всего при одновременном повреждении нескольких связок.
Травма связок может косвенно вызывать хруст в колене. Хруст и щелчки возникают из-за нарушения анатомии сустава, что приводит к неравномерному распределению нагрузки. При разрыве связок сустав изнашивается, что приводит к его повреждению и деформации.
Поражение сухожилий коленного сустава
Повреждение сухожилий, как и связок коленного сустава, может вызывать хруст. Яркие клинические симптомы проявляются при повреждении сухожилия четырехглавой мышцы бедра, отвечающей за разгибание колена. Полный разрыв сухожилия может привести к кровоизлиянию в суставную полость, а хруст особенно выражен при разрыве в области прикрепления к надколеннику. Травмы колена часто становятся основными причинами повреждения сухожилий.
Хондромаляция надколенника как причина хруста в колене
Хондромаляция надколенника — это заболевание, характеризующееся разрушением хрящевой ткани на задней стороне надколенника. Хрящ теряет толщину, что может проявляться как локально, так и широко. На его поверхности образуются трещины. С прогрессированием болезни дегенеративные изменения затрагивают также мыщелки бедренной кости. Патология часто встречается у спортсменов. Основные причины хондромаляции включают травмы коленного сустава, хронические перегрузки и аномалии в развитии надколенника. Главный симптом — боль, усиливающаяся при незначительных нагрузках. При движениях в коленном суставе слышны хруст или щелчки.
К какому врачу обратиться, если хрустит колено?
Основными специалистами по выявлению причин хруста в колене являются травматолог, ортопед и ревматолог. Это связано с тем, что хруст часто обусловлен заболеваниями и травмами опорно-двигательного аппарата. Врачи проводят осмотр пациента, акцентируя внимание на жалобах и клинических симптомах, что помогает установить диагноз. Для подтверждения или исключения заболеваний назначаются лабораторные и инструментальные исследования. На основе результатов обследования врач может точно определить диагноз и назначить лечение.
Если вы столкнулись с хрустом в колене, можно обратиться к следующим специалистам:
- семейный врач;
- терапевт;
- диетолог.
Семейный врач может выявить хруст, связанный с хроническими заболеваниями коленного сустава. Терапевт диагностирует причины хруста, связанные с воспалительными процессами, такими как артрит. К диетологу стоит обратиться при ожирении, которое часто приводит к проблемам с коленными суставами.
Диагностика причин хруста в колене
Диагностика заболеваний, проявляющихся хрустом и щелчками в колене, включает клинические, лабораторные и инструментальные методы.
Ключевые методы для выявления причин хруста в колене:
- клиническое обследование;
- общий анализ крови;
- биохимический анализ крови;
- общий анализ мочи;
- ультразвуковое исследование (УЗИ) коленного сустава;
- рентгенография коленного сустава;
- анализ синовиальной жидкости;
- артроскопия коленного сустава;
- компьютерная томография (КТ) коленного сустава;
- магнитно-резонансная томография (МРТ) коленного сустава;
- сцинтиграфия.
Клиническое обследование
Клиническое обследование пациента включает выслушивание жалоб, сбор анамнеза, осмотр и физикальное обследование, включая пальпацию и аускультацию, а также оценку объема движений в коленных суставах.
Обследование начинается с анализа жалоб. Хруст в колене чаще отмечают люди старше 40 лет из-за возрастных изменений в суставе. Кроме хруста, пациенты могут испытывать боль, дискомфорт, ограничение подвижности и утреннюю скованность.
При сборе анамнеза важно выяснить наличие травм и заболеваний опорно-двигательного аппарата. Врач уточняет, при каких движениях возникает хруст (сгибание, разгибание, приседание, бег, ходьба). Анализ профессиональной деятельности также важен, так как проблема часто встречается у спортсменов и людей с высокими нагрузками на ноги. Необходимо выяснить, не является ли хруст признаком наследственного заболевания (наличие аналогичных симптомов у родственников).
Во время осмотра могут быть обнаружены следующие симптомы патологии колена:
- отек в области колена;
- гематома (скопление крови в подкожной клетчатке);
- деформация колена;
- симметричность патологических изменений;
- поражение кожи и мягких тканей.
При пальпации в колене ощущается крепитация, если положить ладонь на переднюю часть колена и выполнять движения в суставе. Пальпация также позволяет определить наличие жидкости в суставе, деформацию или патологическую подвижность кости. Ощупываются внешние ориентиры сустава, которые могут смещаться при вывихе или переломе.
Аускультация проводится непосредственно (без фонендоскопа), во время которой пациент выполняет активные или пассивные движения конечностью, и выслушиваются хруст или щелчки.
При оценке объема движений в коленном суставе сначала анализируются активные движения (выполняемые пациентом), затем пассивные (выполняемые врачом). Объем движений измеряется с помощью гониометра, при этом нога изначально находится в выпрямленном положении.
Общий анализ крови
Общий анализ крови — это лабораторное исследование для оценки клеточного состава крови. Для анализа берут 2-3 мл венозной крови. Исследование выполняется на специализированном оборудовании, и результаты доступны через несколько часов. Оно позволяет выявить изменения, указывающие на воспалительные или инфекционные процессы, но не определяет специфические изменения, например, связанные с хрустом в колене.
Ключевые показатели анализа — уровень лейкоцитов и СОЭ (скорость оседания эритроцитов). Увеличение лейкоцитов может указывать на инфекцию, а повышение СОЭ — на воспалительный процесс. Лейкоциты могут быть повышены при остеомиелите — гнойном процессе в костном мозге, возникающем как осложнение перелома. Воспаление с повышенной СОЭ может быть вызвано повреждением мягких тканей колена из-за травм или при ревматоидном артрите.
Биохимический анализ крови
Биохимический анализ крови исследует показатели, отражающие состояние органов и тканей. Для анализа используется венозная кровь, а результаты обычно известны в течение суток. Ключевыми показателями при заболеваниях коленного сустава являются ревмопробы — анализ, выявляющий воспалительные процессы. В ходе исследования определяются ревматоидный фактор, АСЛ-О (антистрептолизин-О) и СРБ (С-реактивный белок). Уровень мочевой кислоты также важен, так как его повышение может указывать на подагрический артрит.
Общий анализ мочи
Общий анализ мочи — стандартный метод обследования, результаты которого обычно доступны в течение суток. Хотя в анализе нет специфических показателей для заболеваний колена, гиперурикурия, наблюдаемая при подагрическом артрите, может служить косвенным признаком (увеличение уровня мочевой кислоты в моче).
УЗИ коленного сустава
Ультразвуковое исследование (УЗИ) – метод диагностики, основанный на способности ультразвуковых волн проходить через ткани с различной плотностью и отражаться от них. Отраженные сигналы улавливаются датчиком и выводятся на экран. УЗИ коленного сустава – эффективный способ диагностики заболеваний колена, особенно для изучения мягких тканей. Этот метод доступен и может быть выполнен в большинстве медицинских учреждений. К его преимуществам относятся безопасность и невысокая стоимость. Специальная подготовка не требуется.
Во время визуализации передних и боковых частей сустава пациент располагается на спине. Для более четкого изображения менисков врач может попросить его согнуть ноги в коленях. Чтобы исследовать задние отделы коленного сустава, пациента просят лечь на живот.
Признаки патологий колена, выявляемые с помощью УЗИ:
- Выявление выпота в суставной полости.
- Воспаление синовиальной оболочки с утолщением и разрастанием ворсинок.
- Разрывы связок и сухожилий, проявляющиеся нарушением анатомической структуры и разрывом волокон.
- Поражения менисков: изменение линии контура, деформация, фрагментация и дегенерация.
- Присутствие инородных тел в суставной полости при проникающих ранениях или переломах.
- Киста Беккера, представляющая собой полость, заполненную жидкостью.
- Сужение суставной щели, указывающее на синовит, остеоартрит или ревматоидный артрит.
- Неровные контуры сустава при воспалительных и дегенеративных заболеваниях.
- Истончение гиалинового хряща, часто наблюдаемое при остеоартрите.
- Воспаление синовиальных сумок, проявляющееся анэхогенными (черными) или гиперэхогенными (белыми) зонами.
Рентгенологическое исследование коленного сустава
Рентгенологическое обследование широко применяется для диагностики заболеваний коленного сустава благодаря своей информативности, доступности и невысокой стоимости. Однако этот метод связан с лучевой нагрузкой на организм.
Основные рентгенологические признаки заболеваний колена:
- Изменение положения костей наблюдается при вывихах, переломах бедренной кости и костей голени, а также при врожденных аномалиях опорно-двигательного аппарата.
- Изменение костной структуры чаще всего возникает при переломах, проявляясь в нарушении контакта между костными балками. К изменениям также относится остеопороз (уменьшение плотности) и остеосклероз (увеличение плотности) костной ткани.
- Сужение суставной щели наблюдается при дистрофических и воспалительных процессах. Оно может быть равномерным или неравномерным, причем последнее чаще встречается при артритах.
- Очаги деструкции на рентгеновских снимках выглядят как затемненные или просветленные участки.
- Линия перелома представляется в виде светлой полосы с неровными краями, что позволяет определить ее местоположение (внутрисуставной или внесуставной) и оценить направление и длину.
- Смещение костных отломков может быть поперечным, продольным, боковым или угловым.
- Хрящевые включения и хондромные тела различных форм и размеров могут быть выявлены при хондроматозе.
Рентгенография не всегда четко визуализирует поражения мягких тканей опорно-двигательного аппарата, поэтому рекомендуется использовать другие методы диагностики (КТ, МРТ, сцинтиграфия).
Исследование также проводится после вправления вывихов и лечения переломов для контроля эффективности терапии.
Исследование синовиальной жидкости
Анализ синовиальной жидкости проводится в лаборатории. Исследование включает макроскопическую оценку, микроскопический и микробиологический анализ, а также изучение физико-химических характеристик. Образцы получают путем пункции коленного сустава.
При заболеваниях коленного сустава могут наблюдаться изменения следующих параметров:
- Цвет. Желтоватый оттенок указывает на остеоартроз, кровянистая окраска характерна для травм. Воспалительные процессы могут изменить цвет от желтого до коричневого.
- Прозрачность. При остеоартрозе синовиальная жидкость полупрозрачная, при воспалительных заболеваниях — мутная.
- Осадок. При ревматоидном артрите в жидкости часто обнаруживается осадок из некротизированных участков синовиальной оболочки, напоминающий рисовые зерна («рисовые тельца»).
- Цитоз (количество клеточных элементов). Нормальный цитоз составляет 0,1 – 0,5х10^9/л. При дегенеративных заболеваниях и травмах он может увеличиваться до 2 – 3х10^9/л, а при воспалительных — до 80х10^9/л.
- Микроскопическое исследование. В нативном (неокрашенном) мазке могут быть обнаружены рагоциты (зернистые клетки), количество которых при ревматоидном артрите достигает 50% от общего клеточного состава. При подагрическом артрите выявляются кристаллы мочевой кислоты.
- Неклеточные элементы. При травмах в синовиальной жидкости могут находиться фрагменты хряща и поврежденных связок.
- Клеточный состав. Преобладание определенных клеточных элементов помогает уточнить диагноз и степень заболевания. При воспалительных процессах преобладают нейтрофилы, при дегенеративных — лимфоциты. Например, при ревматоидном артрите нейтрофилы могут составлять до 90%, а при остеоартрозе лимфоциты — до 70%.
Артроскопия коленного сустава
Артроскопия коленного сустава — это хирургическая процедура для диагностики и лечения. Она выполняется под анестезией с использованием артроскопа — инструмента, вводимого в полость сустава через два небольших разреза: один для артроскопа, другой для хирургических инструментов. Все действия контролируются на экране. Для улучшения видимости в сустав вводится специальная жидкость. Артроскопия минимизирует повреждение тканей, что сокращает время восстановления.
Патологические изменения, выявляемые при артроскопии коленного сустава:
- разрыв мениска;
- хондромные тела;
- повреждение хрящевой ткани;
- рассекающий остеохондрит;
- травмы крестообразных связок;
- воспаление синовиальной оболочки.
При выявлении патологий колена во время артроскопии часто сразу же проводится их лечение.
КТ коленного сустава
КТ — эффективный метод послойного анализа состояния костей и суставов коленного сустава, хотя мягкие ткани отображаются менее четко.
Во время компьютерной томографии выполняются послойные снимки, что позволяет получить полное представление о состоянии колена.
КТ коленного сустава помогает выявить:
- переломы костей;
- воспаление синовиальной оболочки;
- жидкость в суставной полости;
- артрит;
- остеоартрит;
- инородные тела в суставе;
- аномалии развития сустава;
- рассекающий остеохондрит.
Специальная подготовка перед КТ не требуется, но процедура противопоказана беременным. Результаты доступны сразу после завершения исследования.
КТ может проводиться с контрастными веществами для улучшения визуализации кровоснабжения в области исследования.
МРТ коленного сустава
Магнитно-резонансная томография коленного сустава обладает высокой информативностью. В отличие от компьютерной томографии, МРТ лучше визуализирует мягкие ткани.
Специальная подготовка перед МРТ не требуется. При клаустрофобии пациенту могут предложить успокоительное, так как во время процедуры он окажется в тоннеле томографа. МРТ противопоказана пациентам с металлическими протезами и имплантатами.
С помощью МРТ коленного сустава можно выявить:
- отек тканей вокруг сустава;
- жидкость в суставной полости;
- растяжение связок и сухожилий;
- повреждения надколенника;
- кисту Бейкера;
- гемартроз;
- синовит;
- бурсит.
Сцинтиграфия
Сцинтиграфия — это диагностическая методика, основанная на введении в вену радиофармацевтических препаратов (РФП), содержащих технеций. Эти препараты накапливаются в тканях организма с разной интенсивностью, а результаты отображаются в виде сцинтиграммы. Нормальное накопление РФП должно быть равномерным. Важны как участки с повышенным, так и с пониженным накоплением. Слабое накопление, или «холодные очаги», может указывать на некроз костной ткани или нарушения обмена веществ. Повышенное накопление РФП наблюдается при артритах, переломах и опухолях. Сцинтиграфия помогает выявить аномальные участки накопления РФП, что может указывать на патологии колена, однако точный диагноз установить невозможно из-за высокой чувствительности и низкой специфичности метода. Для уточнения диагноза назначаются дополнительные инструментальные исследования.
Что делать, чтобы колени не хрустели?
Чтобы устранить хруст в колене, необходимо лечить заболевания, его вызывающие. Терапия должна быть комплексной, включая устранение причины хруста и восстановление функций сустава. Основные методы лечения — хирургия и медикаменты.
При травмах колена важно обеспечить неподвижность конечности с помощью транспортной иммобилизации, используя специальные шины или другие средства для фиксации.
Лечение заболеваний, вызывающих хруст в колене, должно включать:
- соблюдение диеты;
- медикаментозное лечение;
- хирургическое вмешательство;
- восстановительную терапию.
Соблюдение диеты при хрусте в колене
В некоторых случаях диета играет ключевую роль в лечении, особенно при ожирении и подагре. При подагре важно ограничить продукты с высоким содержанием пуринов, чтобы предотвратить накопление солей мочевой кислоты. Пурины, содержащиеся в мясных и рыбных изделиях, а также в некоторых фруктах и овощах, таких как брокколи, цветная капуста и финики, превращаются в мочевую кислоту.
При ожирении правильное питание также критично. Диету следует разрабатывать индивидуально с помощью специалиста-диетолога. Для достижения результатов необходимо сочетать диету с физической активностью. Соблюдение диеты без консультации с врачом может привести к нежелательным последствиям.
Для восстановления фосфорно-кальциевого обмена стоит увеличить потребление продуктов, богатых легко усваиваемым кальцием и фосфором, таких как сыр, молоко, творог и рыба.
Медикаментозное лечение хруста в колене
Медикаментозное лечение применяется при заболеваниях, сопровождающихся хрустом в колене. Оно может быть основным направлением терапии или сочетаться с хирургическими методами. Лечение бывает местным и системным.
Из-за множества причин хруста в колене используются различные группы лекарственных средств.
Медикаментозное лечение хруста в колене
| Группа препаратов | Примеры препаратов | Механизм действия | Способы применения |
| Нестероидные противовоспалительные средства(НПВС) | ибупрофен; диклофенак. | Обезболивают, уменьшают отечность и воспаление. | местно (кремы, гели); перорально. |
| Кортикостероиды | преднизолон; гидрокортизон; триамцинолон. | Обеспечивают противовоспалительное действие. | Внутрисуставные инъекции. |
| Противоподагрические препараты | аллопуринол; колхицин. | Уменьшают образование мочевой кислоты и купируют приступы подагрического артрита. | Перорально. |
| БПВП(базисные противовоспалительные препараты) | метотрексат; циклоспорин; азатиоприн. | Замедляют разрушительные процессы в суставе и ускоряют восстановление. | Внутримышечные инъекции. |
| Витаминно-минеральные комплексы | комплексы с витаминами Д, кальцием и фосфором. | Восстанавливают структуру костной и хрящевой ткани, помогают при рахите. | Перорально. |
| Хондропротекторы | хондроитин сульфат; глюкозамин; гиалуроновая кислота. | Питают хрящевую ткань, замедляют дегенеративные процессы и стимулируют регенерацию. | Перорально; внутримышечные инъекции; внутрисуставные инъекции. |
Хирургическое лечение хруста в колене
Хирургическое вмешательство назначается, когда консервативные методы не обеспечивают выздоровление пациента.
Основные типы хирургических операций для лечения заболеваний коленного сустава:
- артротомия коленного сустава;
- тенорафия;
- артропластика коленного сустава;
- лечебная пункция коленного сустава;
- синовэктомия;
- синовкапсулэктомия;
- артроскопия;
- остеосинтез;
- менискэктомия;
- лечение повреждений связок.
Артротомия коленного сустава
Артротомия выполняется для вскрытия суставной полости с целью удаления патологического содержимого и инородных тел. Это более травматичное вмешательство по сравнению с артроскопией. Доступ к суставу может быть передним, задним или парапателлярным (сбоку от надколенника), причем парапателлярный разрез считается наименее травматичным.
Тенорафия
Тенорафия – операция по сшиванию сухожилий, показанная при резаных или колотых ранениях. Накладываются швы на сухожилия, после чего конечность иммобилизируется на 4–6 недель для нормального срастания. Швы должны быть надежными и не нарушать кровоснабжение.
Артропластика коленного сустава
Артропластика восстанавливает структуру и функции сустава, часто назначается при заболеваниях с контрактурой.
Этапы артропластики коленного сустава:
- артротомия;
- разъединение суставных поверхностей;
- моделирование сустава;
- обездвиживание конечности;
- разработка сустава с помощью упражнений.
Эндопротезирование – замена поврежденного сустава на искусственный, который подбирается индивидуально, сохраняя биомеханику и объем движений.
Лечебная пункция коленного сустава
Пункция проводится для введения лекарств и удаления патологического содержимого, что снижает внутрисуставное давление. Перед процедурой необходимо убедиться, что жидкость находится в суставе. Иглу вводят у края надколенника на глубину 3–4 см, после чего накладывается асептическая повязка.
Синовэктомия
Синовэктомия – операция по удалению синовиальной оболочки, обычно назначается при ревматоидном артрите, когда воспаление не поддается медикаментозному лечению. Удаленная оболочка заменяется синтетической.
Синовкапсулэктомия
Синовкапсулэктомия – удаление синовиальной оболочки и капсулы коленного сустава, назначается на поздних стадиях артрита с выраженным поражением.
Артроскопия коленного сустава
Артроскопия – распространенная операция, выполняемая с использованием артроскопа и видеосистемы. Анестезия может быть местной, спинномозговой или общей. Процедура подходит для повреждений менисков, остеоартроза и травм связок. В сустав подается физиологический раствор для улучшения визуализации, что делает операцию минимально травматичной.
Остеосинтез
Остеосинтез – операция по репозиции костных отломков при переломах с использованием фиксирующих устройств. Фиксация может быть шинированием или компрессией, отломки фиксируются до полного сращения.
Менискэктомия
Менискэктомия – удаление менисков, может быть полной или частичной, выполняется открытым или эндоскопическим методом. Эндоскопическая менискэктомия менее травматична и требует небольших разрезов.
Лечение повреждений связок
Оперативное лечение при полном разрыве связок включает наложение швов на поврежденную связку. В сложных случаях может потребоваться аутопластика или аллопластика. После операции конечность иммобилизуется на 4–6 недель.
Восстановительное лечение при хрусте в колене
Восстановительный этап в лечении хруста в колене — финальная стадия. После медикаментозных и хирургических методов, направленных на восстановление структуры суставных элементов, реабилитация фокусируется на восстановлении функций сустава. Этот период особенно важен после операций на коленном суставе.
Для восстановления функций сустава применяются следующие методы:
- Лечебная физкультура (ЛФК). ЛФК — ключевой элемент в лечении заболеваний колена. Ее использование должно быть обоснованным: слишком ранние физические нагрузки могут усугубить повреждения, а запоздалые упражнения затруднят восстановление функций коленного сустава.
- Физиотерапия. Физиотерапия использует физические факторы для лечения. К методам, применяемым для устранения причин хруста в колене, относятся электрофорез (введение медикаментов с помощью электрического тока), массаж и тепловые процедуры. Комплексное применение этих методов дает значительные результаты.
- Плавание положительно влияет на обменные процессы в организме. Его преимущество при заболеваниях колена — отсутствие нагрузки на сустав, что отличает его от других видов физической активности.
Особенности хруста в колене
Хруст в колене проявляется при движениях в суставе, чаще всего при сгибании, разгибании и приседаниях. Механизм его появления варьируется в зависимости от движений. Обычно хруст сопровождается болевыми ощущениями.
Почему хрустят колени при разгибании и сгибании?
Сгибание и разгибание коленного сустава — распространенные движения, в которых участвуют структуры, предотвращающие чрезмерные движения, такие как переразгибание. К ним относятся внутрисуставные связки, суставная капсула, хрящи и мышцы. Эти движения происходят как при выполнении упражнений, так и во время ходьбы. Хруст в колене при сгибании и разгибании часто указывает на повреждение его структур.
Хруст может быть физиологическим, возникающим при малоподвижном образе жизни, или патологическим, связанным с заболеваниями колена. Патологический хруст возникает из-за трения между поврежденными суставными поверхностями, обычно из-за деформации суставного хряща или воспаления синовиальных сумок коленного сустава.
Почему хрустит колено при приседании?
Данная проблема часто встречается у спортсменов, так как приседания — одно из основных упражнений. При их выполнении нагрузка ложится на мышцы бедер, голени и коленный сустав, что делает симптомы коленной патологии заметными.
Если у человека есть проблемы с коленом, приседания могут вызывать раздражение сустава, приводя к воспалению синовиальной оболочки. Это нарушает питание суставного хряща, что ведет к его разрушению и повреждению суставных поверхностей, вызывая трение. К патологиям, сопровождающимся хрустом при приседаниях, относятся повреждения связок, остеоартрит, артрит и травмы менисков.
Почему хрустит и болит колено?
Хруст и дискомфорт в колене часто связаны между собой из-за схожих причин. Они могут быть острыми, например, травмы коленного сустава, или хроническими, связанными с возрастными изменениями и дегенеративными процессами, такими как остеоартрит.
Боль и хруст в колене возникают из-за нарушения конгруэнтности сустава и истончения гиалинового хряща, что приводит к трению суставных поверхностей. Эти симптомы чаще всего проявляются при движении и могут возникать по утрам после сна или к вечеру после длительных нагрузок на сустав.
Почему хрустит колено у ребенка?
Хруст в колене у ребенка может быть вызван травмами, заболеваниями или чрезмерными нагрузками на сустав. Поскольку опорно-двигательный аппарат детей формируется, любые травмы или патологии могут привести к повреждениям колена и хрусту. Анатомические особенности детских костей, такие как низкое содержание минералов, делают их гибкими, но менее прочными.
Хруст в колене у ребенка может быть вызван следующими состояниями:
- Врожденные аномалии. Это нарушения в развитии костей и суставов, проблемы с синтезом коллагена, а также варусная (О-образная) и вальгусная (Х-образная) деформация нижних конечностей.
- Травмы коленного сустава. В детском возрасте травмы могут привести к серьезным повреждениям из-за хрупкости костей и суставов. Чаще всего такие травмы происходят при падениях. У новорожденных травмы могут быть родовыми.
- Недостаток питательных веществ. Кальций, фосфор и витамин D важны для здоровья костей и суставов. Недостаток витамина D может привести к рахиту, который поражает кости, суставы, нервную систему и мышцы. Нарушение обмена фосфора и кальция может вызвать повышенную хрупкость костей.
- Ювенильный ревматоидный артрит. Это заболевание суставов у детей, причины которого не до конца выяснены. Иммунная система начинает воспринимать собственные ткани как чуждые, что приводит к их повреждению. Заболевание сопровождается воспалением синовиальной оболочки, накоплением синовиальной жидкости и разрушением хряща. Симптомы включают боль в суставах, хруст и отечность колена.
- Остеопороз. Это состояние характеризуется снижением плотности костной ткани, что делает кости хрупкими. Остеопороз у детей может быть врожденным из-за нарушений внутриутробного развития или приобретенным, связанным с неправильным питанием и медикаментами.
Хруст в колене у новорожденных и младенцев часто связан с врожденными заболеваниями, тогда как у подростков он чаще возникает из-за травм или недостатков в питании.
Почему хрустят колени при подъеме по лестнице?
При подъеме по лестнице многие испытывают хруст в коленях. Это связано с движениями в коленном суставе, на который ложится основная нагрузка. При каждом шаге нагрузка распределяется между суставами, что может вызывать хруст. Часто это следствие гиподинамии, когда человек ведет малоподвижный образ жизни. Наиболее распространенные причины хруста в колене при подъеме по лестнице — патологии коленного сустава.
Основные патологии, вызывающие хруст в колене при подъеме по лестнице:
- Гонартроз — дегенеративное заболевание, которое с возрастом становится более распространенным. При гонартрозе нарушается синтез синовиальной жидкости, ухудшается состояние суставного хряща, что приводит к его разрушению и хрусту.
- Повреждение менисков. Одна из частых травм коленного сустава, чаще всего страдает внутренний мениск. При разрыве его фрагменты могут застревать между суставными поверхностями, вызывая хруст, боль и блокаду.
- Ревматоидный артрит характеризуется воспалением синовиальной оболочки и увеличением секреции синовиальной жидкости, что приводит к разрушению гиалинового хряща. Симптомы включают боль, утреннюю скованность, отек, хруст и щелчки при движении.
- Поражение связок коленного сустава. При повреждении связок нагрузка становится неравномерной, что сопровождается щелчками и хрустом, а также болью при пальпации и движении. Может возникнуть нестабильность коленного сустава, особенно при полном разрыве связок.
Если вы замечаете хруст и щелчки в колене при подъеме по лестнице, обратитесь к врачу для выяснения причин. Не занимайтесь самолечением, так как это может привести к необратимым изменениям в коленном суставе и усугубить ситуацию.
Почему опухают и хрустят колени?
Появление отека и хруста в колене указывает на воспалительный процесс в суставе. Эти симптомы могут возникнуть при повреждении различных анатомических структур колена, чаще всего из-за накопления патологической жидкости (кровь, гной или избыточная синовиальная жидкость) в суставной полости или окружающих тканях. Хруст возникает из-за механического сжатия суставных структур, особенно после травм.
Наиболее распространенные причины отека и хруста в коленях:
- Артрит коленного сустава. Воспалительное заболевание суставов, сопровождающееся болями, отеком и покраснением. Функции сустава нарушаются, движения становятся болезненными и хрустящими. Чаще всего встречается ревматоидный артрит.
- Повреждение менисков. Наиболее распространен разрыв менисков, который может произойти в области переднего или заднего рога, а также в теле мениска, что приводит к блокировке сустава. Чаще диагностируются хронические повреждения менисков с разрушением суставного хряща.
- Бурсит коленного сустава. Воспаление синовиальных сумок затрудняет движения. Бурсит может возникнуть из-за травм или воспалительных заболеваний колена (например, ревматоидного или подагрического артрита). Наиболее распространен препателлярный бурсит, проявляющийся отеком чуть выше надколенника, а также болью и хрустом при движении.
- Гонартроз. Возрастные дегенеративные изменения в коленном суставе приводят к постепенному разрушению его структур. С возрастом риск гонартроза увеличивается. Заболевание часто сопровождается хрустом и болями, которые сначала возникают при нагрузках, а затем могут проявляться даже в покое.
Если вы заметили отек и хруст в колене, важно пройти обследование для определения причин и назначения лечения, которое может быть как консервативным, так и хирургическим.
Почему хрустят колени после бега?
При занятиях бегом коленный сустав испытывает значительную нагрузку, особенно при неправильных тренировках. Скорость, ритм и дистанция должны увеличиваться постепенно, а перед пробежкой обязательно нужно делать разминку. Это подготовит тело к физической активности и снизит риск травм. Хруст в колене после бега может возникать из-за неподходящей обуви, которая увеличивает нагрузку на сустав.
Хруст может свидетельствовать о недостаточной физической подготовленности. Если он наблюдается регулярно после бега и сопровождается болью, стоит обратиться к врачу для исключения заболеваний колена.
Хруст в колене после бега может быть вызван следующими состояниями:
- Остеоартроз коленного сустава (гонартроз). Заболевание, при котором происходит разрушение хряща и других структур сустава. Бег не рекомендуется, так как он может ускорить дегенеративные процессы.
- Растяжение связок. Проявляется как полный или частичный разрыв волокон, часто из-за отсутствия разминки перед бегом.
- Повреждение менисков – распространенная проблема, сопровождающаяся хрустом в суставе во время и после бега.
- Бурсит коленного сустава. Воспаление синовиальных сумок, возникающее из-за чрезмерной нагрузки на сустав.
- Внутрисуставные свободные тела. Структуры, свободно перемещающиеся в полости сустава, такие как фрагменты хряща или менисков. Они могут блокировать сустав и ограничивать подвижность, вызывая хруст и щелчки.
Если вы заметили хруст в колене после бега, рекомендуется обратиться к врачу, так как это может быть признаком заболевания или травмы. В таких случаях лучше временно прекратить бег или заменить его на менее травмоопасные виды спорта, такие как плавание.
Вопрос-ответ
Что означает хруст в колене при сгибании и разгибании?
Хруст в колене — это звук, возникающий во время сгибания и разгибания сустава. В клинической медицине такой звук называется крепитация. На первый взгляд этот хруст кажется безобидным, однако он может свидетельствовать о наличии ортопедических заболеваний.
Что нужно принимать, если хрустят колени?
Какие витамины принимать при хрусте в коленях? При хрусте в коленях необходимы следующие витамины: кальций, витамин D, А, Е, С, группы B (В1, В5, В6, В12), а также Омега-3 жирные кислоты.
Почему щелкает колено без боли?
Щелчки в колене обычно связаны с несколькими факторами. Чаще всего это пузырьки газа, образующиеся в синовиальной жидкости. Они лопаются при движении сустава, создавая характерный щелчок. Такие звуки также вызываются трением связок или сухожилий, когда они скользят по костным выступам или другим структурам.
Советы
СОВЕТ №1
Обратите внимание на свою физическую активность. Регулярные упражнения, направленные на укрепление мышц вокруг коленного сустава, могут помочь снизить хруст и щелчки. Упражнения на растяжку и укрепление, такие как приседания, выпады и плавание, могут улучшить стабильность сустава.
СОВЕТ №2
Следите за своим весом. Избыточная масса тела создает дополнительную нагрузку на коленные суставы, что может привести к хрусту и болям. Поддержание здорового веса поможет снизить риск развития патологии и улучшить общее состояние суставов.
СОВЕТ №3
Не игнорируйте симптомы. Если хруст в колене сопровождается болью, отеком или ограничением подвижности, обязательно обратитесь к врачу. Раннее выявление и лечение заболеваний, таких как остеоартрит или бурсит, могут предотвратить дальнейшие осложнения.
СОВЕТ №4
Используйте правильную обувь. Неподходящая или изношенная обувь может негативно сказаться на состоянии коленных суставов. Выбирайте обувь с хорошей амортизацией и поддержкой, чтобы снизить нагрузку на колени при ходьбе и физических нагрузках.